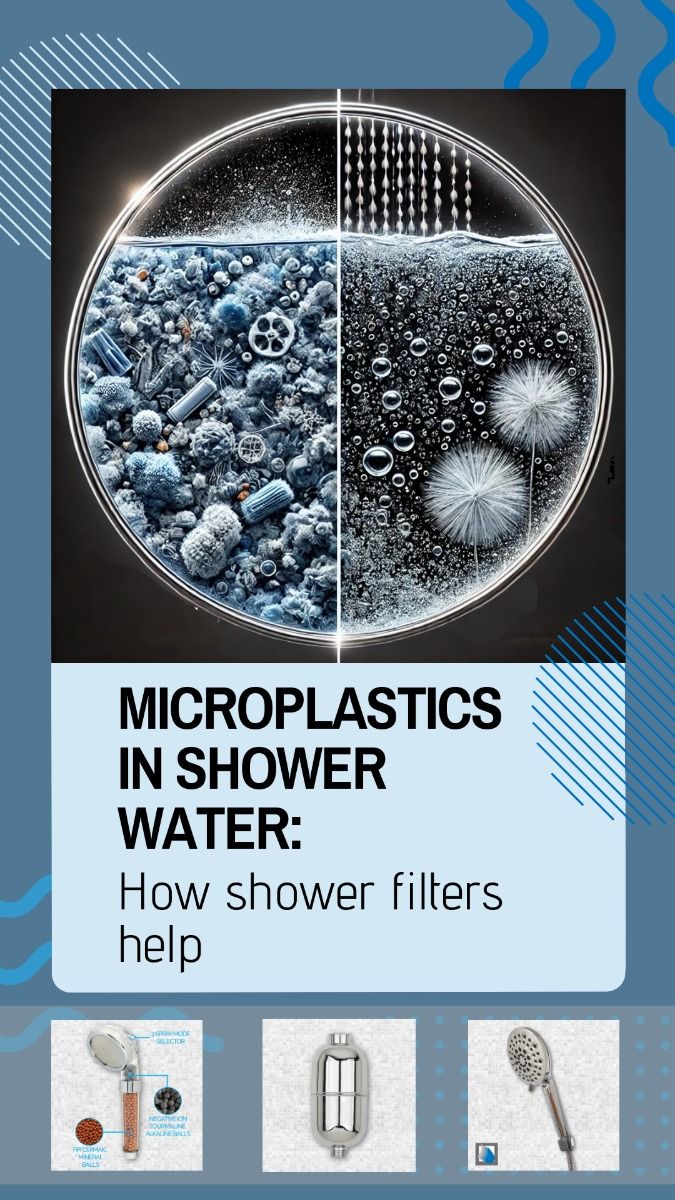

หลายคนลงทุนกับสกินแคร์ราคาแพง แชมพูสูตรพรีเมียม หรือทรีตเมนต์บำรุงผมเป็นประจำ แต่กลับมองข้าม “คุณภาพของน้ำ” ที่สัมผัสผิวและเส้นผมทุกวัน ทั้งที่น้ำคือปัจจัยพื้นฐานที่สุดที่ส่งผลต่อผิว หนังศีรษะ และสุขภาพในระยะยาว นี่คือเหตุผลที่ เครื่องกรองฝักบัว Kohler กลายเป็นอุปกรณ์ที่บ้านยุคใหม่เลือกใช้มากขึ้น เพราะช่วยยกระดับคุณภาพน้ำตั้งแต่ต้นทาง โดยไม่ต้องปรับปรุงระบบประปาทั้งบ้าน
บทความนี้จะพาไปทำความเข้าใจเครื่องกรองฝักบัว Kohler อย่างเป็นระบบ ตั้งแต่หลักการทำงาน เหตุผลที่ควรมี เหมาะกับใคร วิธีเลือกและเคล็ดลับใช้งาน เพื่อให้ตัดสินใจได้ตรงกับการใช้งานจริง

เครื่องกรองฝักบัว Kohler คืออะไร
เครื่องกรองฝักบัว Kohler คืออุปกรณ์กรองน้ำที่ติดตั้งระหว่างท่อน้ำและฝักบัว ทำหน้าที่กรองสิ่งปนเปื้อนในน้ำก่อนสัมผัสผิวและเส้นผม เช่น
คลอรีน
ตะกอน สนิม และสิ่งสกปรกขนาดเล็ก
กลิ่นไม่พึงประสงค์
โลหะหนักบางชนิด (ขึ้นกับรุ่นและไส้กรอง)
Kohler เป็นแบรนด์สุขภัณฑ์ระดับโลกที่ให้ความสำคัญกับมาตรฐานวัสดุ ความปลอดภัย และการออกแบบที่ใช้งานได้จริง เครื่องกรองฝักบัวจึงถูกพัฒนาให้ติดตั้งง่าย ใช้งานสะดวก และดูแลรักษาไม่ซับซ้อน
ทำไมน้ำประปาจึงควรผ่านการกรองก่อนอาบ
แม้น้ำประปาจะผ่านการฆ่าเชื้อแล้ว แต่ยังคงมีสารตกค้างและตะกอนบางส่วน โดยเฉพาะ “คลอรีน” ซึ่งเป็นสารฆ่าเชื้อที่จำเป็นต่อระบบสาธารณสุข แต่เมื่อสัมผัสผิวและผมเป็นประจำ อาจก่อให้เกิดผลกระทบดังนี้
ผิวแห้ง ตึง ระคายเคืองง่าย
ผมแห้งเสีย ขาดความเงางาม
หนังศีรษะลอก คัน หรือแพ้ง่าย
กลิ่นน้ำที่รบกวนประสบการณ์อาบน้ำ
เครื่องกรองฝักบัวจึงเข้ามาช่วยลดปัญหาเหล่านี้โดยไม่ต้องเปลี่ยนระบบน้ำทั้งบ้าน

เหตุผลที่ควรเลือกเครื่องกรองฝักบัว Kohler
1. มาตรฐานวัสดุและความปลอดภัย
Kohler เลือกใช้วัสดุที่ผ่านการรับรองด้านความปลอดภัยสำหรับน้ำใช้ ไม่ปล่อยสารตกค้าง และทนแรงดันน้ำได้ดี
2. เทคโนโลยีการกรองที่เน้นการใช้งานจริง
ระบบไส้กรองถูกออกแบบให้กรองคลอรีนและตะกอนได้อย่างมีประสิทธิภาพ โดยยังคงแรงดันน้ำที่เหมาะสม ไม่ทำให้น้ำไหลอ่อน
3. ติดตั้งง่าย ไม่ต้องดัดแปลงระบบ
สามารถติดตั้งแทนที่ท่อเดิมได้ทันที เหมาะกับทั้งบ้าน คอนโด และอพาร์ตเมนต์
4. ดีไซน์เรียบ หรู เข้ากับห้องน้ำทุกสไตล์
สไตล์ของ Kohler เน้นความเรียบ เท่ และใช้งานได้นาน ไม่ตกเทรนด์
5. บำรุงรักษาง่าย
เปลี่ยนไส้กรองตามรอบที่กำหนด ไม่ต้องมีความรู้ช่างเฉพาะทาง
เครื่องกรองฝักบัว Kohler เหมาะกับใคร
ผู้ที่มีผิวแห้ง แพ้ง่าย หรือผิวบอบบาง
ผู้ที่ทำสีผม ยืด ดัด หรือทำเคมีเป็นประจำ
ครอบครัวที่มีเด็กหรือผู้สูงอายุ
ผู้อยู่อาศัยในคอนโดหรือเมืองใหญ่
ผู้ที่ต้องการยกระดับคุณภาพชีวิตในห้องน้ำ

หลักการทำงานของเครื่องกรองฝักบัว Kohler
โดยทั่วไป เครื่องกรองฝักบัว Kohler จะใช้ไส้กรองหลายชั้น เช่น
ชั้นกรองตะกอน (Sediment Filter)
สารดูดซับคลอรีน เช่น Activated Carbon
วัสดุปรับสมดุลน้ำบางประเภท
น้ำจะไหลผ่านชั้นกรองเหล่านี้ก่อนออกจากฝักบัว ช่วยให้น้ำสะอาดขึ้น ลดกลิ่น และอ่อนโยนต่อผิวมากขึ้น
วิธีเลือกเครื่องกรองฝักบัว Kohler ให้เหมาะกับการใช้งาน
1. ตรวจสอบแรงดันน้ำในบ้าน
เลือกรุ่นที่รองรับแรงดันน้ำของระบบ เพื่อให้น้ำไหลสม่ำเสมอ
2. พิจารณาความถี่ในการเปลี่ยนไส้กรอง
เลือกรุ่นที่มีรอบเปลี่ยนไส้เหมาะกับจำนวนผู้ใช้งาน
3. ดูความเข้ากันกับฝักบัวเดิม
เครื่องกรองควรเชื่อมต่อกับฝักบัวมาตรฐานได้โดยไม่ต้องใช้อะแดปเตอร์เพิ่ม
4. เลือกตามพื้นที่ติดตั้ง
ห้องน้ำขนาดเล็กควรเลือกดีไซน์กะทัดรัด ไม่เกะกะสายตา
เคล็ดลับใช้งานให้คุ้มค่าและยืดอายุไส้กรอง
ล้างระบบก่อนใช้งานครั้งแรก
เปลี่ยนไส้กรองตามรอบที่ผู้ผลิตแนะนำ
หลีกเลี่ยงการถอดเข้า–ออกบ่อย
ตรวจสอบการรั่วซึมหลังติดตั้ง
ใช้ร่วมกับฝักบัวคุณภาพดีเพื่อประสิทธิภาพสูงสุด
เครื่องกรองฝักบัว Kohler กับการดูแลผิวและผมในระยะยาว
เมื่อคุณภาพน้ำดีขึ้น ผิวจะสูญเสียความชุ่มชื้นน้อยลง ผมคงสีและความเงางามได้นานขึ้น การดูแลผิวและผมจึงมีประสิทธิภาพมากขึ้นโดยไม่ต้องเพิ่มขั้นตอนหรือค่าใช้จ่ายด้านผลิตภัณฑ์อื่นมากนัก
อุปกรณ์เล็กที่เปลี่ยนคุณภาพชีวิตได้จริง
เครื่องกรองฝักบัว Kohler คือการลงทุนที่คุ้มค่าในระยะยาว ช่วยยกระดับการอาบน้ำให้กลายเป็นช่วงเวลาที่ผ่อนคลาย สะอาด และปลอดภัยต่อผิวและผม เหมาะกับบ้านยุคใหม่ที่ให้ความสำคัญกับสุขภาพตั้งแต่รายละเอียดเล็กที่สุด

